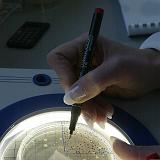

|
|||
|
|||
image |
| Merkur Spielothek GmbH & Co. KG |
|||
 |
 |
 |
 |
 |
 |
 |

|

|

|

|

|
 |
 |
 |
 |
| Miele & Cie. KG | Jubiläum: 20. Millionen Waschvollautomaten | ||
 |
 |

|

|

|

|

|

|

|

|

|

|

|

|

|

|

|

|

|

|

|

|

|

|

|

|

|

|

|

|

|

|

|

|

|

|
| Friedhof St. Pankratius | |||

|

|

|

|

|

|

|

|
| Gymnastikverein Isselhorst | |||
 |

|

|

|

|

|

|

|

|

|

|

|

|

|

|

|
| Ruderboot-Idylle |

|

|
|
| Marten Vertriebs GmbH & Co. KG |
Produktion | ||

|

|

|

|

|

|

|

|

|

|

|

|
| Bertelsmann AG | Hauptverwaltung | ||

|

|

|

|

|

|

|

|

|

|

|

|

|

|

|

|

|

|

|

|

|

|

|

|

|

|
 |
 |
| Kinderspielplatz Kletterwand | |||

|

|

|

|
| Diakonie Gütersloh e.V. | Immigranten | ||

|

|

|

|
| Diakonie Gütersloh e.V. | Freizeitheim für Kinder und Jugendliche | ||

|

|

|
 |

|

|

|

|
| Diakonie Gütersloh e.V. | Tagespflege | ||

|
 |
 |

|

|
 |

|

|

|

|

|
 |
| Diakonie Gütersloh e.V. | Ausländerinnen lernen Deutsch | ||

|

|

|

|
 |
 |
 |

|
 |

|

|
 |

|

|
 |
 |
| Stadtwerke Gütersloh GmbH | Wasseranalyse | ||
|

|

|

|

|

|

|

|

|

|

|

|
| nach oben | |||